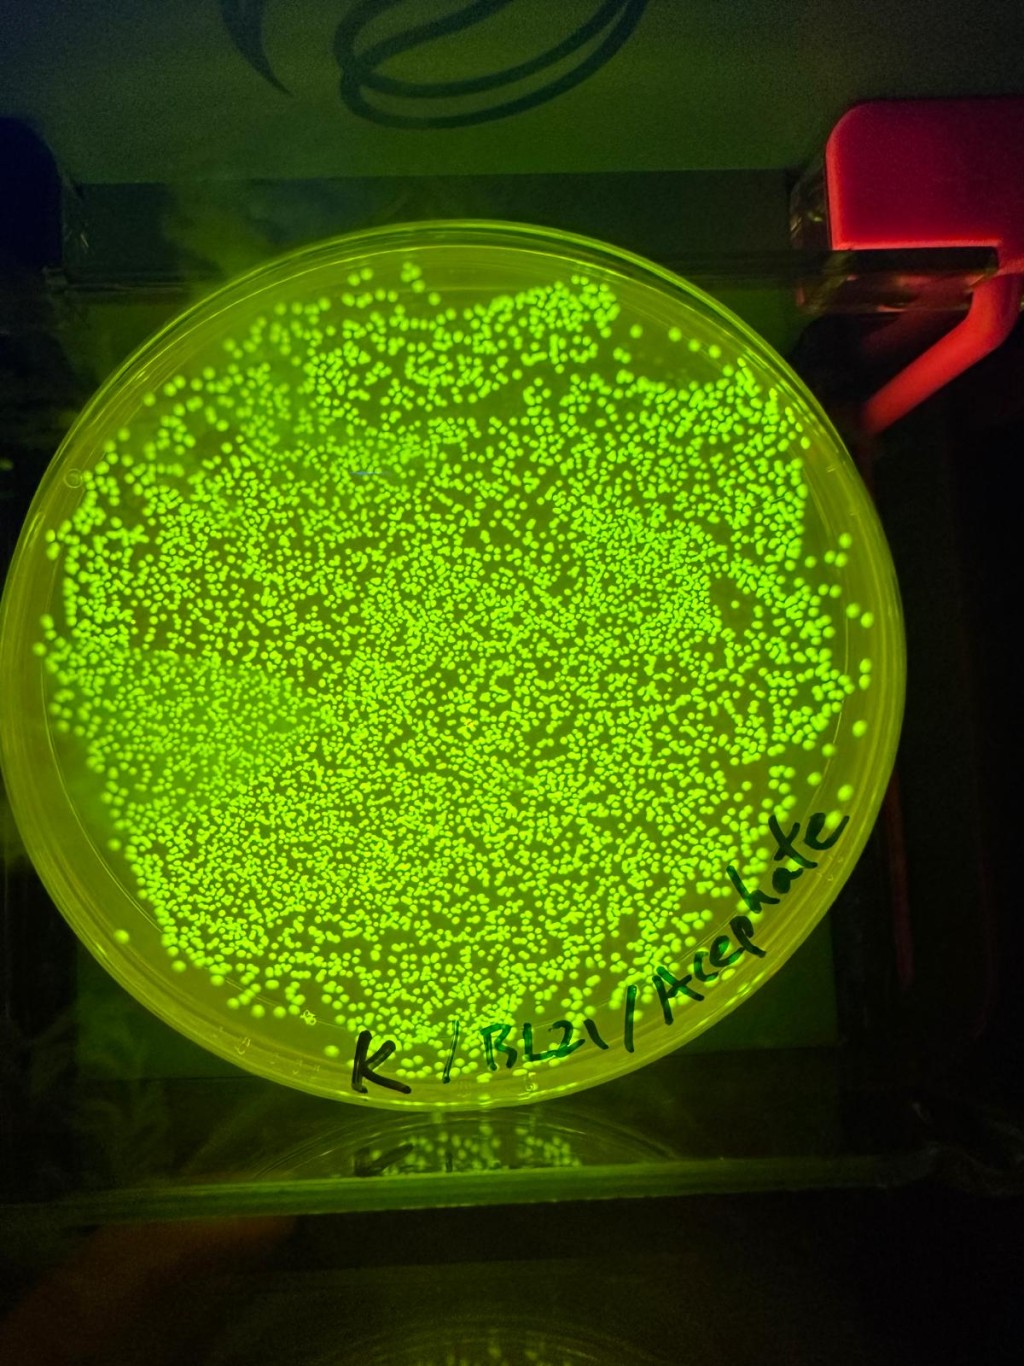
「PestiGuard」採用嶄新基因電路技術,以可量化的視覺輸出呈現檢測結果。受訪者提供 「PestiGuard」採用嶄新基因電路技術,以可量化的視覺輸出呈現檢測結果。受訪者提供

中學科研|聯校中學生組隊 研創新農藥檢測技術 國際基因工程大賽奪金 躋身世界前10
發佈時間:12:11 2025-11-06 HKT
在今年的國際遺傳工程機器設計競賽 (iGEM) 中,由六所中學學生組成的香港聯校隊伍,憑藉能檢測農藥的創新研究項目「PestiGuard」,在超過100支高中隊伍中脫穎而出,不僅勇奪高中組金獎,還成功躋身全球高中組前十強,並於專項獎項名列前茅。團隊成員表示,是次佳績啟發他們對科研的熱情,未來將致力於解決全球食品安全及環境污染等問題。
採用嶄新技術 螢光顯示農藥濃度

香港中學聯隊的成員來自迦密柏雨中學、東華三院伍若瑜夫人紀念中學、九龍真光中學、華英中學、聖公會聖三一堂中學及民生書院。他們的研究項目「PestiGuard」,是一款創新的生物感測器,能夠檢測食品中的農藥殘留,藉此提升消費者的食品安全意識。

「PestiGuard」採用嶄新基因電路技術,以可量化的視覺輸出呈現檢測結果。當農藥分子與適配體結合時,會抑制螢光蛋白的表達,從而令螢光信號減弱。感測器能因應農作物的農藥濃度,呈現不同深淺的螢光信號。信號越亮,代表農藥濃度越低;信號越暗,則代表濃度較高。為了讓檢測更精準便捷,團隊還開發了一款名為「BioAP」的手機應用程式。用戶只需拍攝檢測結果,程式便能自動分析並計算出農藥濃度。此外,程式亦提供數據存儲、檢測結果追蹤及數據刪除功能。
在研究的過程中,團隊向科學家、食品安全專家及公眾收集建議,不斷改良,以確保技術的實用性與科學性。在法國舉行的iGEM Grand Jamboree現場,團隊發表研究報告,並展示科學海報及攤位,即場回應評審及其他參賽隊伍的提問,顯示他們的科學素養與溝通能力。
團隊成員:十分自豪與感恩 望繼續投身科研事業

「PestiGuard」在今年的iGEM脫穎而出,奪得高中組金獎,並打入高中組別世界前十。在專項獎項亦表現優異,於「最佳模型」排全球前五名、「最佳軟件」獲全球第二名及「最佳環境組別」獲全球前五名。
對於今次獲得的佳績,團隊成員都表示十分自豪與感恩。他們認為,參與 iGEM 不僅增長了知識,更啟發了他們對科研的熱情與抱負。未來,他們希望繼續投身科研事業,致力於解決全球食品安全及環境污染等重大問題,並以科技創新造福人類。
延伸閱讀:
研抗藥細菌試劑 中大生iGEM奪金 冀助中低收入國家醫護「對症下藥」

















